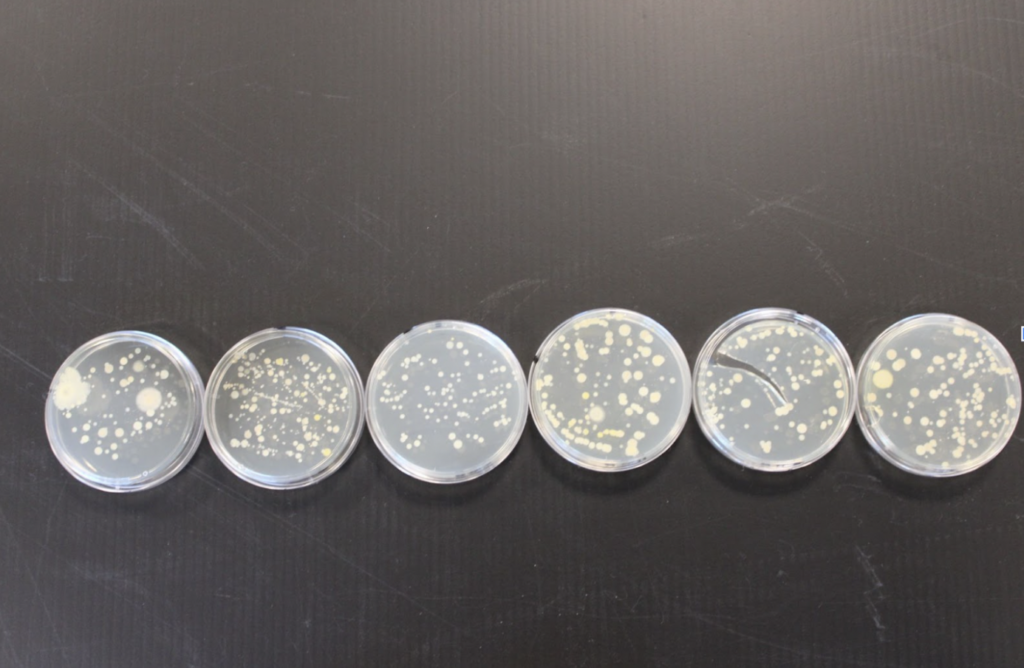
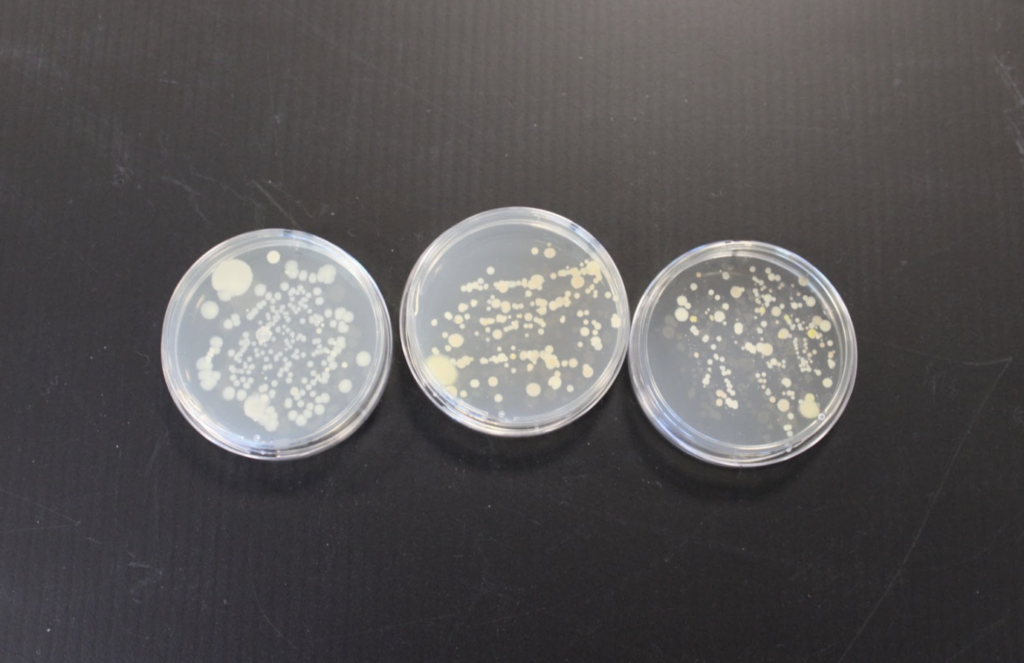

Everyone has their go-to bathroom stall. Whether it’s the biggest one for some extra space or the one furthest from others for added privacy, each person has unique reasons for their favorite place to do their business.
I have always been a second-stall type of person. That is until I became aware of an interesting theory: the first stall is the cleanest because everyone is too afraid to use it. “I don’t want to go in the first one, because I assume people use it more, so it’s dirtier,” senior Sara Nordlund said.
The group of bathroom-goers who use the first stall because of reverse psychology might feel like they have cracked the code by choosing the stall that everyone else is too afraid to squat on (trust me, I am one of them). Opting for the first stall may seem like a unique choice, but it may not be as savvy as it sounds.
This theory was investigated in a 1995 study. This experiment followed the rate of toilet paper depletion in four stalls over a 10-week period. 60% of finished rolls were found in the middle two, while the remaining 40% came from the first and last stalls. This suggests that—contrary to popular belief—middle stalls are the most favored.
When students were polled on an Instagram story about which stall they would pick, the bias against the first stall persisted. 344 students responded to the M-A Chronicle poll, and 30% of people chose the last stall, making it the most popular. This stall is commonly the biggest, which could play a role in its favorability. The second most favored stall was three, followed by stall four, stall one, and lastly, stall two.
Besides toilet paper use and preferred stall choices, the best way to test the cleanliness of the M-A bathrooms is bacteria growth. I swabbed each toilet seat in the G-Wing downstairs boy’s and girls’ bathrooms at the end of the school day and incubated them for three days to allow growth.
Girls’ stall three was the clearest of the petri dishes, suggesting that it was the cleanest. The rest of the stalls shared a similar level of bacteria growth. This could be due to the fact that the first stall is the home of those unable to hold it until they reach a further one. The first stall may be less used in general, but it seems to be most used in bathroom emergencies.
In the boys’ bathroom, the first stall was the most populated, which could reflect a general preference for efficiency with boys. While we may not be sure of the exact causes of the growth, we can be sure that no stall is clear of it.
Some people’s preferences change based on which stalls they feel are commonly occupied, which could account for inconsistent data from varying opinions to skew it from the study. “I’ve always gone to the second stall because someone is almost always in the one right next to the wall,” senior Addy McCombs said.
When it comes to urinals, proximity to others is perhaps the most important factor for some. “First, you go to the one furthest away from the door, then the one closest, and then you need to make sure no one is next to you,” junior Quinn Robbins said.
The middle stall users don’t want to make too bold of a choice, finding common ground between the different types. “I use the second biggest one because it’s not the biggest, but it’s still bigger than the normal ones,” sophomore Ashley Mobley said. Fearing the seemingly overused first and biggest stalls, many people end up somewhere in between.
There still is a first-stall community, though it may be less prominent. “I use the one in the beginning because not a lot of people use those,” freshman Belen Yepez said. This exists with urinals as well. “I would go to the first one for efficiency,” junior Axel Pilette said. In hopes of getting in and getting out quickly, Pilette disregards other criteria.
The student survey confirms the rumor that the first stall is the most passed by, but the experimental data proves that it is not necessarily the least contaminated. With all of this information, it’s easy to feel disappointed that your toilet choice is not as genius as you think it is, but taking the time to experiment with every stall and having the data to make an educated decision can help to ease the pain of changing spots in the loo. In the end, one thing is clear: those paper toilet seat covers are there for a reason.
